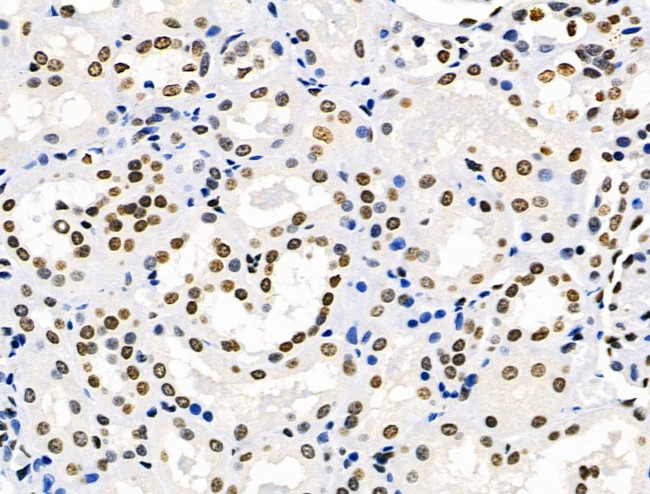
HEF1 Antibody in Immunohistochemistry (Paraffin) (IHC (P))

Search
Invitrogen
HEF1 Polyclonal Antibody
{{$productOrderCtrl.translations['antibody.pdp.commerceCard.promotion.promotions']}}
{{$productOrderCtrl.translations['antibody.pdp.commerceCard.promotion.viewpromo']}}
{{$productOrderCtrl.translations['antibody.pdp.commerceCard.promotion.promocode']}}: {{promo.promoCode}} {{promo.promoTitle}} {{promo.promoDescription}}. {{$productOrderCtrl.translations['antibody.pdp.commerceCard.promotion.learnmore']}}
图: 1 / 6
HEF1 Antibody (PA5-102624) in IHC (P)






Please note: We are reviewing Western blot images included in the antibody testing data in our catalog, including those provided by third parties. Unless expressly labeled or annotated as “raw-unedited”, Western blot images included in the antibody testing data in our catalog may have been edited, optimized or otherwise adjusted for presentation.
产品信息
PA5-102624
种属反应
已发表种属
宿主/亚型
分类
类型
抗原
偶联物
形式
浓度
规格
纯化类型
保存液
内含物
保存条件
运输条件
RRID
产品详细信息
Antibody detects endogenous levels of total NEDD9.
靶标信息
HEF-1 is a multifunctional protein involved in integrin-based signaling that affects cell motility, growth, apoptosis and oncogenic transformation. The Cas family of docking proteins have been the subject of intense research because of their role in cell motility, growth, apoptosis and oncogenic transformation. These proteins are substrates of focal adhesion kinase (FAK) and the Src family of tyrosine kinases two active targets for drug development. HEF1 protein production increases levels of mRNA transcripts that encode proteins associated with motility, cell transformation and invasiveness, including several metalloproteinases, MLCK, p160ROCK and ErbBi. HEF1 overproduction also mediates apoptosis in epithelial-derived cell lines, including MCF7 and HeLa cells. Recent clinical studies at another institution have found that overexpression of BCAR1 (p130Cas), a related protein, is associated with tamoxifen resistance. This highlights the importance of studying the role of this family of proteins in cancer prognosis.
仅用于科研。不用于诊断过程。未经明确授权不得转售。
生物信息学
蛋白别名: Cas scaffolding protein family member 2; CAS-L; CASS2; Crk-associated substrate lymphocyte-specific protein; CRK-associated substrate-related protein; dJ49G10.2; dJ761I2.1; Enhancer of filamentation 1; hEF1; mEF1; NEDD-9; Neural precursor cell expressed developmentally down-regulated protein 9; neural precursor cell expressed, developmentally down-regulated gene 9; p105; Renal carcinoma antigen NY-REN-12
基因别名: Cas-L; CASL; HEF1; MEF1; Nedd-9; NEDD9; p105
UniProt ID: (Mouse) O35177
Entrez Gene ID: (Rat) 291044, (Mouse) 18003